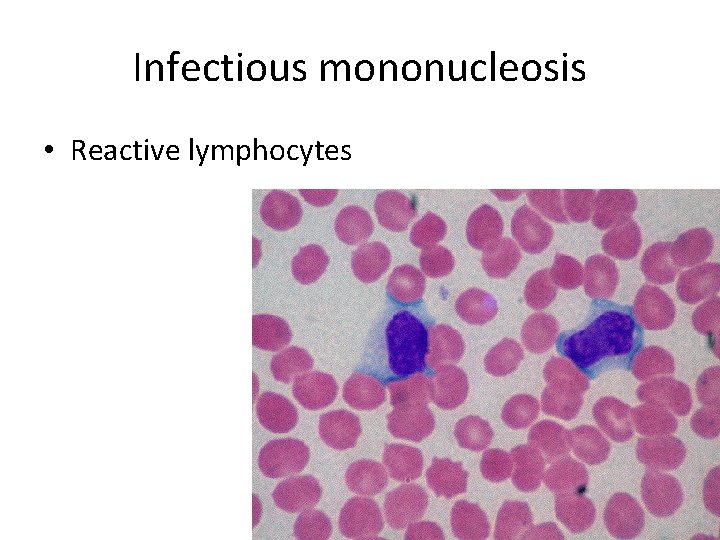
Infectious mononucleosis • Reactive lymphocytes
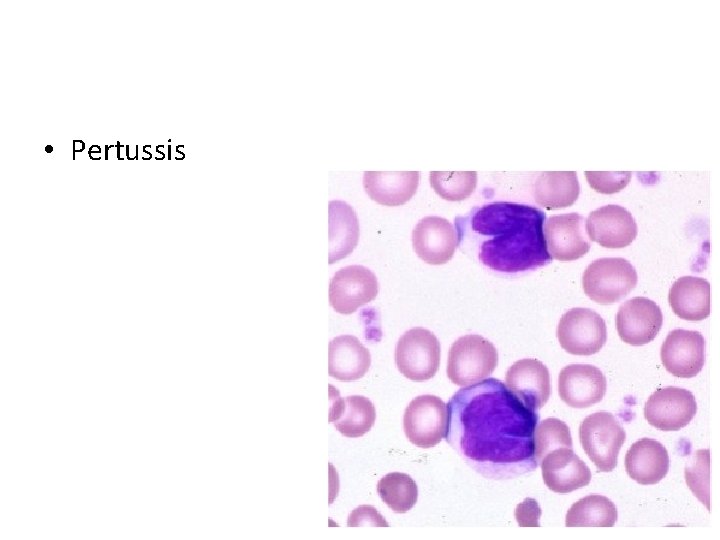
• Pertussis

Pathology 6 White blood cell and lymph node

Pathology 6 White blood cell and lymph node disorders (1)

• Toxic changes in neutrophils include all the following, except: A. B. C. D. E. Cytoplasmic basophilia Large basophilic granules Hypersegmentation Cytoplasmic vacuoles Dohle bodies

• Large granular lymphoma is associated with A. B. C. D. E. Neutropenia Lymphocytopenia Neutrophilia Eosinophilia Basophilia

• Monocyopenia is associated with which one of the following tumors A. B. C. D. E. Lymphoplasmacytic lymphoma Chronic lymphocytic leukemia Large granular lymphoma Hairy cell leukemia Hodgkin lymphoma

Nonneoplastic WBC disorders. • High number (cytosis) • Low number (cytopenia) • Abnormal function

• 5 major types of WBCs – Neutrophils – Lymphocytes – Monocytes – Eosinophils – Basophils

• What is the characteristic finding that lymphocytes display on peripheral blood in patients with pertussis? A. B. C. D. E. Reactive lymphocytes Lymphocytes with cleaved nuclei Normal lymphocytes Prominent nucleoli Hairy cytoplasmic extensions

Neutropenia • Decrease in the number of neutrophils – When severe, it is called agranulocytosis • Usually less than 500 – Increased risk of infection – Two major mechanisms • Decrease production • Increase peripheral destruction of neutrophils

• Decrease production – Marrow hypoplasia in patients who receive chemotherapy – Leukemia or other tumors replacing the marrow – Medications – Certain types of neoplastic lymphocytic proliferations such as large granular leukemia (LGL)

• Increased peripheral use – Autoimmune destruction – Overwhelming bacterial, fungal or rickettsial infection – splenomegaly

Clinical manifestations • Infection, infection!!! – bacterial • Fever, chills, malaise • Mucocutaneous necrotizing ulcers • High risk of sepsis

• Treat with broad spectrum antibiotics • Depending on the clinical setting, treat with GCSF

lymphocytopenia • Low number of lymphocytes – Less than 1000 in adults – Less than 3000 in children <2 years of age

• Increased risk of – Opportunistic infections – Autoimmune disorders – Malignancy

Causes • Acquired: – HIV/AIDS – Protein malnutrition – Viral infections – Autoimmune disorders: SLE and RA – Certain leukemia or lymphoma tumors

• Inherited – Severe combined immunodeficiency – Wiscott-Aldrich syndrome

Clinical manifestations • Infections with unusual microoganisms – Pneumocystis jiroveci – Fungal infections – CMV – Zoster These infection could be fatal • Risk of malignancies • Autoimmune disorders

• Symptoms of associated diseases – Small or absent tonsils or lymph nodes in HIV or immune deficiency diseases – Lymphadenopathy: again in early HIV or lymphoma – Eczema in WAS – Stigmata of pancytopenia in cases of leukemia

Treatment • Treat infections • Treat underlying condition – IVIG for certain types of immune deficiency • Bone marrow transplantation

Monocytopenia • In the setting of other pancytopenia • Associated with hairy cell leukemia

eosinopenia • Can be found in healthy individuals – Of limited clinical significance • Steroid use • Acute inflammatory condition

Basopenia • • Limited clinical significance Acute hypersensitivity Thyrotoxicosis Infection

Neutrophilia • Increased number of neutrophils • Caused by – Acute bacterial infections – Sterile inflammation • Burns • Myocardial infarction – Morphology: TOXIC CHANGES



Toxic changes • Occur in the setting of bacterial infection – Cytoplasmic basophilia – Vacuoles – Dohle bodies

Lymphocytosis • Increased number of lymphocytes – Chronic bacterial infections • TB, brucella • Pertussis • Viral infection – Morphology depends on the cause
Infectious mononucleosis • Reactive lymphocytes
• Pertussis

Monocytosis • Increased number of monocytes – Chronic infections such as TB (associated with lymphocytosis) – Endocarditis – Rickettsial infection – Collagen vascular disease such as SLE – Inflammatory bowel disease – Certain myeloid leukemia with monocytic differentiation

Eosinophilia • • Allergic disorders Parasitic infections Medications Collagen vascular disorders Vasculitis Atheroembolic disorders (transient) Certain myelproliferative neoplasms Certain lymphoma, specifically Hodgkin lymphoma

Basophilia • Rare, • Usually in the setting of chronic myelogenous leukemia.

Reactive lymphadenopathies


Acute nonspecific lymphadenitis • Enlargement of a localized or generalized group of lymph nodes – Localized in cases of draining a site of infection – Generalized viral or bacterial infection

• Painful enlargement of the lymph nodes. • Histology: – Large follicles with germinal center formation – Frequent GC macrophages – Sinus enlargement with histiocytes – Parafollicular neutrophils, necrosis and possible pus formation

Chronic Nonspecific Lymphadenitis • It assumes three patterns – Follicular hyperplasia – Paracortical hyperplasia – Sinus histiocytosis

Follicular hyperplasia

• No neutrophils • Can be confused with follicular lymphoma (1) the preservation of the lymph node architecture; (2) variation in the shape and size of the germinal centers; (3) the presence of a mixture of germinal center lymphocytes of varying shape and size; (4) prominent phagocytic and mitotic activity in germinal centers. (5) BCL 2 is negative in the follicles and positive in follicular lymphoma

• Paracortical hyperplasia – Viral infections – Medications – After vaccines


Sinus histiocytosis

• Toxic changes in neutrophils include all the following, except: A. B. C. D. E. Cytoplasmic basophilia Large basophilic granules Hypersegmentation Cytoplasmic vacuoles Dohle bodies

• Large granular lymphoma is associated with A. B. C. D. E. Neutropenia Lymphocytopenia Neutrophilia Eosinophilia Basophilia

• Monocyopenia is associated with which one of the following tumors A. B. C. D. E. Lymphoplasmacytic lymphoma Chronic lymphocytic leukemia Large granular lymphoma Hairy cell leukemia Hodgkin lymphoma

• What is the characteristic finding that lymphocytes display on peripheral blood in patients with pertussis? A. B. C. D. E. Reactive lymphocytes Lymphocytes with cleaved nuclei Normal lymphocytes Prominent nucleoli Hairy cytoplasmic extensions
- Slides: 46